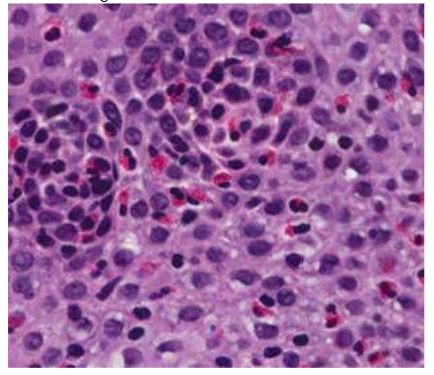
Figure 1. Epitelio esofágico con numerosos eosinófilos. HE X20. Imagen cedida por la Drª L González López. Servicio de A. Patológica del HGU.C Real

Eosinophilic Esophagitis: Latest Insights and Treatments
Eosinophilic Esophagitis: Review and Update
Alejandro Raúl Gratacós Gómez, Ph MD 1; Miriam Clar Castelló 2; Stephanie Bracamonte Odreman 2; Esther Iniesta Tejera 2; Laura Bas Bellver 2; Carmen Garcia Rodriguez 2; Alba M Extremera Ortega Ph MD 2; Alberto Palacios Cañas 2; M Aranzazu Martin Iglesias Ph MD 2; Jesus M Borja Segade 2; Elisa Gómez Torrijos Ph MD 2
- Endocrinology Section, Hospital Universitario, Toledo, Spain
- Allergy Section, Hospital General Universitario Ciudad Real, Spain
OPEN ACCESS
PUBLISHED: 31 August 2025
CITATION: Gratacós Gómez, AR., Castelló, MC., et al., 2025. Eosinophilic Esophagitis: Review and Update. Medical Research Archives, [online] 13(8). https://doi.org/10.18103/mra.v13i8.6864
COPYRIGHT: © 2025 European Society of Medicine. This is an open-access article distributed under the terms of the Creative Commons Attribution License, which permits unrestricted use, distribution, and reproduction in any medium, provided the original author and source are credited.
DOI https://doi.org/10.18103/mra.v13i8.6864
ISSN 2375-1924
ABSTRACT
Background: Eosinophilic esophagitis is a chronic, antigen-mediated disease of the esophagus that causes dysphagia and swallowing in adults, with nonspecific symptoms of esophageal dysfunction and/or alterations in swallowing in children, and sometimes with esophageal stenosis in both unless treatment is prescribed. Characteristics. EoE courses with symptoms of esophageal dysfunction, especially in adults, such as dysphagia and choking. In children, esophageal symptoms are more nonspecific and also involve alterations in swallowing. In addition, they are necessary for the diagnosis of ≥15 eosinophils per field of large increase in at least one biopsy of the esophagus, and other causes of esophageal eosinophilia must be ruled out. Treatment can be with food elimination diets (elementary, empirical, or according to allergy tests), or pharmacological (proton pump inhibitor drugs, deglutidated topical corticoids, and dupilumab). When there is esophageal stenosis, the treatment would be esophageal dilatation.
Objetives: This review offers a general and practical overview of the recent literature on EoE (epidemiology, etiopathogeny, pathophysiology, diagnosis, prognosis, and treatment).
Methods: The team performed a bibliographic search on PubMed between February -2019 tJune-2025. Keywords used in the search: eosinophilic esophagitis, epidemiology, etiopathogeny, pathophysiology, symptoms, diagnosis, natural history, prognosis, therapy/treatment. In total we use reviewed 100 articles on EoE for the preparation of this review and update.
Results: This review provides an updated and comprehensive overview of multiple aspects of eosinophilic esophagitis, as outlined in the study objectives. Each characteristic was analyzed in light of the most recent evidence to reflect current understanding and clinical practice.
Conclusions: Primary eosinophilic gastrointestinal disease affecting the esophagus exclusively, characterized by chronic, antigen-triggered inflammation. Symptoms vary depending on whether they are children or adults. Diagnosis is made by esophageal symptoms and/or alterations in swallowing and ≥15 eosinophils /HPF in at least one of the esophageal biopsies, after ruling out other causes of esophageal eosinophilia. Complications can arise if patients are undiagnosed and untreated, both in the short and long term. EoE is frequently associated with atopic comorbidities. They also tend to have digestive comorbidities, although to a lesser extent. Autoimmune and other connective tissue diseases are not relevant. Treatment may be with food elimination diets or with drugs, and to assess the response to the same is the precise disappearance of the symptoms and eosinophils of the esophageal mucosa.
Keywords:
Eosinophilic esophagitis; epidemiology, etiopathogeny, pathophysiology, symptoms, diagnosis, treatment
Background
Eosinophilic esophagitis (EoE), is defined as a quecud¡r clinicopathological entity with TH2 inflammation and is characterized by symptoms of esophageal dysfunction especially dysphagia and swallowing in adults and more unspecific associated or not to alterations in swallowing in children and the presence of ≥ 15 eosinophils per high field increase (HPF) in one or more esophageal biopsy samples, in the absence of other non-EoE-related disorders that may cause or contribute to esophageal eosinophilia1(Table 1).
History
The EoE has been known by this name since 1993. Although the diagnostic approach to EoE has evolved since the 2007 consensus, the conceptual definition of EoE remains the same. The current diagnostic criteria were established by international consensus during the AGREE Conference and are reinforced by other guideline-drafting bodies. In 2011, the requirement of an assay with PPI for the diagnosis of EoE was eliminated, and later the term PPI-REE. This was based on extensive data showing that before treatment, patients responding to IBPs were clinically, endoscopically, histologically, immunologically, and molecularly similar to patients with EoE without response to IBPs, and that PPI likely were treating EoE through novel mechanisms independent of gastric acid suppression by itself.
OBJECTIVES:
To provide physicians with a general and practical review of the recent literature on eosinophilic esophagitis, including its epidemiology, etiopathogenesis, pathophysiology, diagnosis, prognosis, and treatment
Methods
STUDY SELECTION AND ELIGIBILITY CRITERIA
A comprehensive literature search was conducted in PubMed covering the period from February 2019 to June 2025. The search strategy included the following keywords: eosinophilic esophagitis, epidemiology, etiopathogenesis, pathophysiology, symptoms, diagnosis, natural history, prognosis, and treatment. Titles and abstracts of 1,963 peer-reviewed articles on eosinophilic esophagitis retrieved during this period were screened by the review team. A total of 10 authors participated in this phase, each assessing approximately 200 abstracts.
DATA EXTRACTION
Based on the abstracts, each author selected only those studies that best aligned with the review objectives (approximately 40%) for full-text evaluation. Priority was given in the following order: meta-analyses, clinical trials, systematic reviews, prospective studies, case-control studies, narrative reviews, retrospective studies, case series, and selected case reports. The first author and the corresponding author jointly screened the 800 selected articles using the information provided by the reviewers. Selection was based on relevance to the study objectives, study design, journal, and publication date. Finally, both the first and corresponding authors manually and thoroughly reviewed at least 100 full-text articles included in this update. Additionally, reference lists of selected studies were screened to identify other potentially relevant publications. When critical data were unclear or missing, efforts were made to retrieve the information from the original cited references.
Results
EPIDEMIOLOGY
The literature suggests that prevalence is increasing. The reasons for this increase are little known, and controversy exists as to whether new cases of EoE being diagnosed represent a true increase in prevalence or, rather, increased recognition of the disease with the passage of years.
From 2008 to 2011, the standardized incidence of EE remained stable, but from 2011 to 2018 it increased from 3.9 to 11.7 per-100,000 person-years. In children, the incidence of EoE was a quarter of the incidence in adults aged 40 to 64 years: 4.4 versus 17.6 per-100,000 person-years. The incidence of EoE, according to one study, varied substantially in the five regions of Denmark. This study of the entire population of Denmark during the period 2008 to 2018 shows that the incidence and prevalence of EoE have not yet stabilized and that EoE may be underdiagnosed, especially in children.
EoE also seems to be increasing in Sweden, with an overall age-standardized incidence of EoE of 1.22 per-100,000 person-years in the last decade. The incidence and prevalence of EE in Japan have steadily increased during the last two decades. However, EE remains less common in Japan compared to the United States and Western Europe.
There are ethnic and gender variations in the prevalence of EoE, with most cases reported in Caucasian males. EE predominates in socioeconomically developed countries, with the highest prevalence in the United States, Western Europe, and Australia. In the adult population, Caucasian and non-Hispanic white men are more likely to present with EoE than women of their respective races. EoE can present in all age groups; however, it is more common in men between 20 and 30 years of age, and the mean age of diagnosis is 34 years.
A study revealed evidence of ancestry-specific inheritance of EoE; however, further independent genetic studies on different ancestries for EoE are needed.
The prevalence varies by country and continent. The most recent combined prevalence data demonstrated 34.4 cases/100,000, 42.2/100,000 for adults, and 34/100,000 for children. The incidence of EoE is increasing, perhaps due to increasing awareness of EoE coupled with higher esophageal biopsy sampling rates during esophagogastroduodenoscopy. However, additional evidence suggests a general increase in the incidence of EoE even after taking into account increased awareness of the disease; this phenomenon is also observed for other atopic diseases. The prevalence of EE continues to increase, with a rate of 1:617 in 2022 among those < 65 years and of 1:1562 in 2017 among those <65 years. The general prevalence in EE. UU. was of approximately 1:700. It is estimated that annual costs associated with EoE will top $1300 million by 2024, representing a by no means negligible financial burden.
ETIOPATHOGENY
The triggering of EoE is thought to be multifactorial, with environmental factors, such as food allergens or aeroallergens, host factors, such as antecedents of atopy, and an underlying genetic predisposition. Complete genomic analysis studies demonstrated susceptibility elements at 5q22, such as thymic stromal lymphopoietin and 2p23 Calpain. The ingestion of food allergens provokes a cellular response of TH2 lymphocytes that leads to the activation of cytokines, specifically interleukin (IL)-5 and IL-13. IL-5 participates in eosinophil synthesis and transport, and increased IL-13 induces the production of specific proteins, in particular eotaxin-3, across epithelial cells. The latter is a primary regulator of eosinophils in the gastrointestinal tract. On the other hand, IL-13 induces proteases that impair the epithelial barrier, which in turn reduces the expression of adhesion molecules key to the maintenance of epithelial integrity.
EoE is more common among first-degree relatives of patients with EoE; therefore, they have a higher risk of developing EoE than the general population. In EoE also higher rates of association with some monogenic disorders, such as in connective tissue disorders, have also been observed. In addition, mast cells have been implicated in the inflammatory pathway and remodeling. Accumulating evidence supports allergic etiology as the underlying mechanism of EOE, but the magnitude of the correlation between EE and atopy remains ambiguous. In summary, a complex interplay between genetics, environmental exposures, and cellular and molecular interactions. Studies linking specific genetic risk loci with environmental exposures, with consequent skin barrier dysfunction and allergic hypersensitivity, provide a unifying mechanism for the triggering of EoE.
PATHOPHYSIOLOGY
The esophagus is an immunologically active organ that, normally, lacks eosinophils, but recruits them in response to gastric acid aggressions, infectious stimuli, and swallowed ingested food allergens, as well as inhaled allergens. However, in patients with EoE, the presence of EoE persists as a chronic inflammatory state that causes symptoms and may eventually trigger complications. Epithelial cells constitute an important source of cytokines for TSLP and calpain-14; an altered epithelial barrier function that allows penetration of food-derived antigens and microbiota participates in triggering and maintenance of inflammation. Eosinophil and mast cell-derived products, including TGFβ, along with IL-1β and TNFα, promote mesenchymal epithelial transition in EoE, contributing to tissue remodeling through the synthesis and deposition of extracellular matrix in the subepithelial layers.
There is a significant association between eosinophilic esophagitis and atopy; however, multiple studies have ruled out the role of IgE in its pathogenesis. In turn, results from several studies have demonstrated an elevated IgG4 level in patients with EoE. Numerous genetic, environmental, and immunological factors contribute to epithelial barrier dysfunction in EoE. This leads to a further deviation of the immune response toward a “Th2” phenotype, alterations in the esophageal microbiome, and penetration of relevant antigens into the esophageal mucosa, fundamental factors for the pathophysiology of EoE.
Therefore, we can say that, in EoE, there is a dysregulation between the esophageal epithelium and the immune system. Immune activation of the esophageal epithelium, induced by allergens and biased by TH2 lymphocytes, propagates a cycle of impaired mucosal barrier integrity and allergic inflammation, leading to tissue remodeling and progressive organic dysfunction. Eosinophil predominance inflammation provokes typical wall remodeling, characterized histologically by epithelial and smooth muscle hyperplasia, fibrosis of the lamina propria, and neoangiogenesis. These alterations manifest themselves clinically in a pattern of symptoms that will be commented on in a separate part of the symptoms.
SYMPTOMS
Symptoms in EoE vary depending on whether they are children or adults. The main symptoms associated with EoE in adults are dysphagia, choking, and food bolus impaction. In children, symptoms are usually nonspecific and vary with age, including reflux-like symptoms, growth retardation, dyspepsia, nausea, and vomiting. It is estimated that there is a mean diagnostic delay of EoE of around 5 years, both in children and adults. The longer the disease goes unnoticed and undiagnosed, the greater the likelihood that the patient will present persistent or increasing esophageal eosinophilic inflammation, as well as present symptoms that do not remit and/or develop complications secondary to esophageal fibrosis/stenosis. Early detection depends on the recognition of early clinical manifestations, which vary from childhood to adulthood. The symptoms that present can vary and make it difficult for a doctor to correctly diagnose the disease. Therefore, the knowledge and understanding of physicians from the patient’s perspective is crucial for them to make early and appropriate diagnoses and treatment recommendations. Patients may also see their illness as a series of distinct episodes that justify management with complementary strategies as needed (eg, patients especially children and adolescents take too long to eat, chew slowly and carefully, drink plenty of liquid at meals to enhance the descent of solid foods to through the esophagus, have appetite for liquid or semi-liquid foods). Therefore, these behavioral modifications may mask the impact of their symptoms when consulting their physicians, which may result in delays in diagnosis and treatment. Both children and adults may experience atypical symptoms such as cough, which is often related to food intake (during or after) and food-induced immediate esophageal response syndrome.

Hypervigilance and symptom-specific anxiety are important for understanding self-perceived outcomes by patients with EoE. Physicians should assess for hypervigilance and anxiety, especially in patients with refractory symptoms and low health-related quality of life. It has been demonstrated that there are high social, emotional, and psychological burdens associated with EoE. EE has a significant negative impact on mental health quality of life (QoL), being relevant that, in patients, coping strategies, especially relevant. Therefore, a proactive approach of coping mechanisms is warranted to improve QoL and manage the burden of EoE in patients. In a recently published study, no differences in symptom severity or QoL were identified between male and female patients with EoE.
DIAGNOSIS
In addition to the presence of symptoms compatible with EoE, diagnosis of EoE is necessary in the presence of ≥ 15 eosinophils/ HPF in at least one esophageal biopsy obtained by endoscopy. Given that eosinophils are disseminated irregularly, at least four-six biopsies should be obtained between the distal, medium, and proximal portions of the esophagus. Nonspecific symptoms, reluctance, or lack of access to an invasive procedure are associated with frequent delays in diagnosis, which can provoke irreversible fibrosis in untreated EoE. Familiarize yourself with the typical symptoms of EE and the systematic screening of at-risk populations (ie, people with a family history of EE, atopy, food allergies, and/or multiple respiratory conditions) are measures that may contribute to the early diagnosis of EoE. Diagnosis is usually delayed due to the wide variety of presentations, and in addition, they differ according to age. In infants and young children, who cannot describe their symptoms verbally, the diagnostic latency is up to 2 to 3 years; in one-third of affected adults, it exceeds 10 years even today. It is crucial to perform early diagnosis to effectively control symptoms and prevent the occurrence of complications. For diagnosis, in addition to the symptoms already mentioned, other causes of esophageal eosinophilia must be excluded.
Endoscopy plays a central role in the diagnostic process. There are typical endoscopic images of EOE but they are not pathognomonic, although there may be EoE with absence of endoscopic signs. The EREFS (Edema, Rings, Exudates, Grooves, Stenosis) scoring system has standardized the reporting of the characteristic endoscopic findings associated with EoE. Studies indicate that linear grooves and white exudates are most predictive of eosinophilic infiltration and active inflammation, whereas concentric rings and stenoses often reflect chronic remodeling. Other limitations of the EREFS scoring system include limited sensitivity for fibrostenotic features such as stenoses, variability in scoring between endoscopists, and lack of direct correlation with symptoms, findings in the validation phase. Other technological advances, such as high-resolution imaging and chromoendoscopy, are being evaluated to improve the detection of subtle changes in the mucosa indicative of EoE. However, their cost and availability limit their widespread adoption, especially in resource-limited settings.

The appearance of the esophagus on endoscopy can vary and is not part of the diagnostic criteria, but is important as support. To improve diagnostic sensitivity, it is necessary to perform multiple biopsies to obtain an adequate number of esophageal samples. These biopsies should cover the entire esophageal mucosa. In addition, it is crucial to examine stomach and duodenum samples to rule out other pathologies involving eosinophils, such as eosinophilic gastroenteritis. Multiple biopsies are recommended, even if no abnormalities are observed during endoscopy, as indicated by experts. In a study conducted in children with EoE, more than 25% of patients presented with no apparent abnormalities during the first endoscopy.
The Eosinophilic Esophagitis Histological Scoring System (EoEHSS) is useful for the diagnosis and characterization of EoE. A limitation of the EoEHSS is that lamina propria fibrosis scores are determined infrequently due to the difficulties in obtaining own foil samples. A low distensibility index (DI), measured with the functional imaging probe of the endoluminal lumen (EndoFLIP), is associated with the severity of fibrostenosis in pediatric patients with EoE; therefore, EndoFLIP can complement the EoEHSS to assess esophageal remodeling associated with EoE. The new EoEHSS is a highly reliable diagnostic tool that can provide further information. In addition to helping to establish a diagnosis, the EoEHSS is more capable of assessing disease severity after treatment and has been shown to differentiate between patients who have received treatment for EoE and those with active disease. The EoEHSS is composed of eight components to address grade (severity) and stadium (extent). The eight components are eosinophilic inflammation, eosinophilic abscesses, surface stratification, surface epithelial alteration, dyskeratotic epithelial cells, dilated intercellular spaces, basal zone hyperplasia, and lamina propria fibrosis.
In children and adults, decreased esophageal distensibility may be a marker of early fibrostenotic changes, independent of eosinophil count. Decreased esophageal diameter and cross-sectional area, resulting in lower distensibility, occurs regardless of endoscopic findings, such as grooves, rings, or white plaques. These early changes are important, not only for diagnostic purposes, but also for their prognostic value to characterize the severity of the EoE, since they are associated with food impaction and the need for esophageal dilation. EndoFLIP is a diagnostic tool that uses impedance technology to measure key luminal parameters and features in real time during endoscopy. EndoFLIP can largely complement the EoEHSS and provide data on early esophageal remodeling in EE disease progression.
Alterations of esophageal motility are frequently observed in EoE, derived from chronic inflammation and tissue remodeling. High-resolution manometry studies have identified patterns such as fragmented peristalsis, ineffective esophageal motility, and reduction of the distal contractile integral, all of which correlate with the degree of inflammation and fibrosis. Specifically, reduction of the distal contractile integral is associated with the fibrostenotic phenotype of EoE, which reflects an alteration of esophageal distensibility and muscle contraction. The HIMEOS study, which examined esophageal motility patterns in various EoE phenotypes, highlighted the variability of hypomotility and altered bolus transit with disease chronicity, further supporting manometry as a tool to stratify disease stages and guide management. The alteration of peristaltic coordination in EoE is thought to be due to structural alterations, such as subepithelial fibrosis, that interfere with neuromuscular signaling in the esophageal wall. In addition, transient pressurization patterns observed during high-resolution manometry, in particular panesophageal pressurization, indicate a reduction in esophageal distensibility and stiffness caused by esophageal fibrosis.
The inclusion of impedance along with manometry improves the diagnostic value of pulse manometry when assessing bolus transit efficiency, often altered in EoE. Studies indicate that impedance manometry should identify the food bolus in patients with severe inflammation and esophageal narrowing, offering a functional correlation with endoscopic and histologic findings. Altered bolus transit impedance findings often align with the presence of stenosis or esophageal rings, supporting its role in the assessment of EE. It therefore broadens the scope of manometry by capturing both transit and contractile deficits, providing a more delimited assessment of the severity of EoE. Manometry is also useful in distinguishing EoE from other diseases that course with alterations in esophageal motility, such as achalasia. Therefore, manometry is beneficial to clarify diagnostic uncertainty and optimize the management of EoE. Despite its advantages, manometry is still not fully integrated into routine diagnostic protocols for EE, in part due to the variability of findings and the absence of disease-specific motility indicators.
Transnasal endoscopy can be performed without sedation and consists of introducing a thin endoscope through the nasal folds to the esophagus, where biopsies are obtained. This procedure can be performed on children from the age of six and can be facilitated with virtual reality goggles to distract children from the procedure.
New diagnostic modalities are being evaluated, above all non-invasive techniques, such as esophageal thread testing and cytosponge devices, which have proven promising for monitoring eosinophilic activity without the need for repeat endoscopies. These methods are especially beneficial for the pediatric population. Serum biomarkers, such as eotaxin-3 and periostin, are being investigated as possible complements to endoscopic and histological evaluations. While preliminary studies indicate their usefulness for monitoring disease activity, further validation is needed to integrate these biomarkers into usual clinical practice.
The availability of a noninvasive, rapid, real-time clinical marker for EoE would be mutually beneficial for physician and patient, but currently, numerous limitations hinder integration of multiple biomarkers studied in body secretions (blood, urine, feces, and esophageal secretions) into usual clinical practice in EoE. In one study, they have observed the expression of several genes relevant to EoE in salivary secretion; if these findings are validated, it could be very beneficial for patients and for physicians managing this disease.
DIFFERENTIAL DIAGNOSIS
The differential diagnosis must be made with all causes of esophageal eosinophilia, such as EGIE (see Table 1), and of dysphagia.
GERD, EoE, and celiac disease (CD) can coexist and present similar symptoms. Its distinction usually involves an upper digestive endoscopy, esophageal biopsies, pHmetry, and celiac serologies. EoE should be considered when patients with GERD do not respond to treatment with proton pump inhibitors (PPIs) or when patients with EC present persistent esophageal symptoms despite a gluten-free diet. EC should be considered if dysphagia is accompanied by ferropenic anemia, malabsorptive diarrhea, or osteoporosis.
Lymphocytic esophagitis is an infrequent disease, but increasingly recognized. Given that his symptoms and endoscopic appearance are nonspecific, a high degree of suspicion for the symptoms, mucosal sampling, and histopathological analysis is mandatory to make the diagnosis, as a lymphocytic infiltrate with peripapillary distribution and absence of eosinophilic granulocytes is typical. The endoscopic appearance can vary widely, from a “normal”-appearing mucosa (33% of patients) to narrowing, esophageal rings, linear grooves, and trachealization. It is worth highlighting that approximately 40% of patients may present with an endoscopic appearance indistinguishable from EoE. In EoE, there is no consensus on the minimum number of intraepithelial lymphocytes diagnosis of lymphocytic esophagitis, although in the literature, there are some case described with at least 40 lymphocytes /HPD that improves significantly with IBP.
COMPLICATIONS
EoE does not seem to affect life expectancy, but it does affect quality of life since no association between esophageal cancer and EE has been found.
Short-term complications have been described in patients with active or undiagnosed EoE, such as Food impaction, tears, and esophageal perforations. The latter two usually occur when attempting to resolve an impaction spontaneously or by endoscopy. Vomiting-induced esophageal perforation is a potentially serious complication of EoE. Therefore, EoE should be evaluated in patients with nontraumatic Boerhaave syndrome, especially in young men with a history of dysphagia and allergies. Food impaction that does not resolve spontaneously may motivate a visit to the emergency service or an urgent endoscopy.
Upper digestive endoscopies performed to resolve food impaction may provoke complications such as esophageal perforation and/or esophageal tears due to friability of the esophageal mucosa. In addition, vertical lacerations of the mucosa and breakage or emesis-induced tears in the tissue lining the esophagus may appear after esophageal dilatation performed for the treatment of esophageal stenosis or may even appear spontaneously.
Acute intramucosal dissection of the esophagus (AIE) is a rare complication of eosinophilic esophagitis. In patients with EE with high clinical suspicion of acute DEI, we suggest early performance of a chest computed tomography and contrast esophagography, thus avoiding potentially hazardous endoscopic procedures in the acute phase that may contribute to dissection enlargement or progression to perforation. Once the diagnosis of DEI is confirmed, even in the presence of a contained perforation, conservative treatment with multidisciplinary management should always be considered.
Recently, a pediatric study has been published in which they conclude that 5% of EoE cases treated with topical corticosteroids presented with adrenal insufficiency.
However, there is concern that prolonged and uncontrolled inflammation can cause irreversible structural changes in the esophagus, resulting in tissue fibrosis, stenosis formation, and impaired esophageal function.
COMORBIDITIES
Patients with EoE usually have concomitant atopic diseases. The clinical and epidemiological associations between EoE and other allergic manifestations are well established. In addition to the exaggerated rates of atopic dermatitis, IgE-mediated food allergy, asthma, and allergic rhinitis in patients with EoE, each of these allergic manifestations entails an individual and cumulative risk for the subsequent diagnosis of EoE.
EoE shares clinical features, immunologic pathways, susceptibility locus, and risk with atopic affections such as food allergies, asthma, allergic rhinitis, and Atopic Dermatitis. EoE and IgE-mediated food allergy (IgE-FA) are food-triggered diseases. Both pathologies share numerous clinical linkages, including significant comorbidity and similar food triggers. Like atopic diseases, they may share prior mechanisms related to barrier function and signals that lead to the TH2 response. A recent work revealed that 40.6 % of children diagnosed with EoE were also diagnosed with IgE-FA, and that children with IgE-FA had a nearly 4-fold higher rate of EoE compared with children with other atopic affections.
EoE is an infrequent, but concerning, side effect of oral immunotherapy (OIT) and sublingual immunotherapy (SLIT). IgG4 could provide an early and intermediate degree of tolerance to anaphylaxis (such as that observed during ITO to food allergens), while allergen-specific TH2 cells are activated and may contribute to the development of EoE. Further studies are needed to better elucidate the factors related to ITO, SLIT, subcutaneous immunotherapy (SCIT), and with patients that may predispose to the development of an EoE. The presence of EoE or preexisting subclinical EoE may account for some cases of EoE identified during ITO and even be a comorbidity rather than a complication.
Digestive comorbidities in patients with EoE appear in lower numbers than atopic comorbidities. In a study with patients diagnosed with EoE, the most frequent was chronic gastritis, followed by Helicobacter pylori infection; others, such as autoimmune comorbidities and collagenosis, were irrelevant.
Therefore, Patients with EoE are more likely to present comorbid atopic diseases, which favors the allergic diathesis of EoE. Physicians in general and allergists, gastroenterologists, and pediatricians in particular should keep present that allergic patients with upper gastrointestinal symptoms may have an EoE.
NATURAL HISTORY
Initially, EoE was a rare disease; over the years, it has become increasingly prevalent, with global estimates exceeding 140 cases per-100,000 people. Due to this increase the need to better understand the natural history of EoE and disease evolution to ground diagnostic and treatment strategies is relevant. The evidence suggests that EoE is a progressive condition, such that untreated inflammation contributes to esophageal remodeling and fibrotic complications over years or decades. Patients may develop esophageal food impactions, leading to emergency room utilization due to the occasional need for urgent endoscopy. Also, patients with fibrostenotic disease may require serial dilations. Long-term treatment shows promising results for modifying disease evolution. However, there is variability in the solidity of the evidence on the ability of each therapy, in particular, to arrest or reverse fibrosis. There is no consensus on the definition of fibrosis, the identification of progression-prone phenotypes, and the tailoring of therapies to each patient.
The natural history of untreated EoE represents a steady progression from an inflammatory to a fibrostenotic phenotype. Four large retrospective studies clearly demonstrated that the duration of untreated EoE, expressed as diagnostic delay, constitutes the main risk factor for esophageal remodeling and esophageal stenosis formation.
In a cohort study with more than 10 years of follow-up, children with EoE with a period of histologic disease control and were diagnosed at earlier ages were less likely to develop esophageal stenoses. This suggests that histologic remission is associated with a reduction in remodeling complications. Childhood-onset EoE appears to be a progressive disease from childhood to adulthood, albeit with more inflammatory-type symptoms after the transition compared with those with adult-onset EoE.
ROLE OF ALLERGOLOGISTS IN EOE
Taking into account that patients with EoE are mainly allergic individuals and knowing that part of the research on this disease focuses on finding less invasive monitoring techniques, the key means by which allergists can contribute to the diagnosis and treatment of EoE. Physicians with this specialty can participate in detecting subtle symptoms of EoE in their allergic patients, help optimize treatment of other allergic comorbidities, provide training on elimination diets, and facilitate follow-up of the disease over time. Allergists are in a unique position to comprehensively treat the entire allergic individual, rather than just EoE, and should be prepared to treat these patients alongside gastroenterologists.
Control of concomitant atopic comorbidities is essential to ameliorate the evolution of EoE. Allergists have extensive knowledge of botany and zoology, as well as panallergens of plant and animal origin, and their possible cross-reactivities, especially between allergens of the same family. An allergist can be the GP for the management of EoE in collaboration with a gastroenterologist-endoscopist. This strategy has advantages, as allergists have experience in the management of atopic disorders in patients with EoE. It is also valuable from a practical point of view and in cases where EoE is triggered by a therapeutic modality used as therapy for other atopic diseases. In addition, allergists can interpret skin tests and serum analyses to detect allergen sensitization in order to facilitate diagnosis and treatment of other atopic diseases, and we currently have biological therapies with which several atopic diseases, including EoE, can benefit. Therefore, if the main management is performed by a gastroenterologist, patients with EoE should be referred to Allergology consultations for an evaluation of their concomitant atopic diseases.
Current methods of food allergy testing (skin puncture tests or specific serum IgE tests), which identify IgE-mediated sensitization, do not identify triggers of EoE, nor any other atopic disease, and, therefore, should not be performed to identify food triggers of EoE. The tests may be considered in cases of comorbid IgE-mediated food allergy or for the evaluation of allergic rhinoconjunctivitis. Physicians should discourage food allergy testing if the patient eats foods without a history of immediate reactions. Testing can be performed in select cases if there has been a significant period of avoidance of specific foods in an atopic individual, given the risk of loss of tolerance over time, to facilitate reintroduction.
Some cases of occupational EoE have been described, referring to EoE triggered exclusively by exposure/inhalation of aeroallergens in the workplace. In the context of an allergic process, an occupational etiology must be considered; we can suspect occupational EoE in cases with a suggestive personal background. In the case of a patient diagnosed with occupational allergic respiratory disease, with symptoms of esophageal dysfunction, the patient undergoes a full clinical history, with maximum detail on working conditions: space and surroundings, recent specific work, schedule, rest, holidays, air conditioning, and ventilation systems. Occupational EoE is triggered by inhalation of aeroallergens, although if these are present in food, EoE can also be triggered by ingestion of said allergen (orally). To confirm an occupational origin, the patient should avoid exposure to aeroallergens and not ingest them orally. An esophagoscopy with sectional biopsies will be performed at 2 months to determine if the EoE has remitted. Subsequently, the patient may ingest the aeroallergen, but must continue to avoid its exposure. Esophagoscopy with biopsies should be repeated after another 2 months. If remission persists, EoE is triggered by the respiratory route, and if reactivated, it is triggered by aeroallergens by both routes (respiratory and oral). A correct diagnosis requires a high index of suspicion and a temporal relationship between symptoms and work. An incorrect diagnosis can have critical socioeconomic consequences for the patient. In Spain, Royal Decree 1299/2006 of 10 November (amended 4 May 2018) establishes the official criteria for classification and recognition. Occupational physicians from an occupational health service may act as consultants and guide allergists in the medico-legal field. However, the ideal management of EoE would be with a multidisciplinary team to achieve remission of the disease in the shortest possible time and without adverse effects.

PRONOSTIC
The long-term prognosis of patients with EoE is unknown. Some patients may present with an evolution with ups and downs, characterized by symptomatic episodes followed by periods of remission. Cases of apparent spontaneous remission of disease have also been described in some patients; however, the risk of recurrence in these patients is unknown. Prolonged, untreated disease may cause esophageal remodeling that causes stenosis, Schatzki ring, and, ultimately, achalasia. Progressive remodeling appears to be gradual, but not universal. Similarly, the duration of untreated disease seems to be the best predictor of stenosis risk.
One study concludes that it is unlikely that untreated asymptomatic EoE and mild symptomatic EoE will worsen, even without treatment, at least during the 7-year follow-up. In turn, the localized type may improve spontaneously, implying a possibly different pathogenesis than the diffuse type. Additional studies should clarify the long-term prognosis.
Another study provides information on the natural evolution of asymptomatic EoE and the effects of treatment with PPI or a potassium-competitive acid blocker. The treatments produced an improvement in most cases; however, disruption provoked a worsening in some cases. Some patients with asymptomatic EoE presented an improvement without treatment, whereas others developed symptoms, highlighting the importance of long-term follow-up and individualization of therapeutic decisions.
Most patients with EoE with severe stenosis (≥15 mm) experienced an improvement in esophageal diameter to ≥15 mm with treatment (medical or dietary, along with repeated esophageal dilations), suggesting that currently available treatment options are effective for patients with severe stenosis. The most significant factors associated with disease reversibility are initial esophageal diameter and histologic remission.
ASSESSMENT OF EOE ACTIVITY AND TREATMENT RESPONSE
Potential markers for assessing EoE activity and treatment response include symptoms, endoscopic signs, and histology with eosinophil count. There is variability in the literature regarding therapeutic evaluation criteria, which limits the interpretation of data on treatment response. Recently, changes in symptom severity and endoscopy have begun to be reported with the help of new patient-reported outcomes and quality of life questionnaires, as well as a standardized endoscopic scoring system.
To standardize symptom reporting by patients with EoE, symptom assessment tools, such as the EoE Activity Index (EoEAI) and the Dysphagia Symptom Questionnaire for adult patients with this disease, have recently been developed. These tools can complement biological activity parameters in assessing the overall burden of EoE.
In EoE, symptoms do not correlate with histology, and there are no surrogate markers that provide information on esophageal inflammation. Obtaining biopsies is necessary to assess long-term disease progression. The gold standard for assessing disease progression remains histological evaluation with sedated upper endoscopy and multiple biopsies from different esophageal sections. The timing of follow-up endoscopy varies, but it is generally recommended 8 to 12 weeks after starting or changing treatment with PPIs or steroids. If treatment is with diet, follow-up endoscopy can be performed between 6 and 8 weeks. Generally, follow-up times for dupilumab can be closer to 6 months. It is recommended that endoscopic findings of EoE be assessed with the validated EoE Endoscopic Reference Score (EREFS) and histological features be assessed with the validated Histologic Severity Score. Symptoms should also be assessed. Although not yet considered a standard of care, the EE Severity Index (EE-SSI) is a physician-reported metric for monitoring disease severity and is undergoing validation.
Treatment
Standard regimens, such as elimination diets, PPI, and oral topical steroids, do not achieve remission in all patients. Furthermore, the loss of efficacy and concerns about the long-term safety of medical treatments are growing concerns.
Once the diagnosis is established, the goals of treatment are as follows: (A) resolution of symptoms, (B) treatment of eosinophil-rich inflammation, and (C) prevention of fibrostenotic complications. Symptom resolution can be achieved by treating inflammation and fibrostenotic disease with endpoints of esophageal eosinophilia ≤ 15 eos/high-density field and esophageal luminal diameter greater than 15 mm. Treatment of EoE can be summarized as the “3 Ds”: drugs, diet, and dilation. According to current guidelines, PPIs, topical steroids, and exclusion diets are considered first-line therapeutic options. The choice depends on several factors, including age, symptom severity, and lifestyle. Lack of response to one therapy leads to consideration of one of the remaining alternatives.
Standard treatments include dietary elimination, proton pump inhibitors, and topical corticosteroids, while biologic therapies such as dupilumab offer targeted alternatives for refractory cases.
PPIs are used at high doses for EoE (usually omeprazole 40 mg twice daily in adults and 1–2 mg/kg/day in children) and are generally approximately 30–50% effective in inducing remission. PPIs are generally very safe medications, with rare adverse effects, such as the possibility of infections, decreased absorption of vitamins and nutrients, or renal impairment. The mechanisms of PPI effectiveness are thought to be partly related to the inhibition of eotaxin through the K+/H+ ATPase in esophageal epithelial cells in a calcium channel-dependent manner.

Transcriptional analyses in PPI-treated esophageal epithelial cells suggest that inhibition of IL-13 and its downstream effector cascades may also be involved, particularly through the activation of the aryl hydrocarbon receptor by PPIs. Long-term clinical and histological remission rates for approximately 3.5 years after PPI introduction were approximately 60%, indicating long-term effective therapy.
Furthermore, a retrospective review of 18 patients who were initially refractory to PPIs and were then treated with topical corticosteroids that induced remission and were then retreated with PPIs as maintenance therapy.
Oral topical corticosteroids are among the best-evaluated drugs for efficacy and safety in EoE. In a technical review of eight studies with 437 enrolled patients, treatment with topical budesonide or fluticasone had a histological response rate in approximately two-thirds of subjects, although recent trials of budesonide orodispersible tablets had response rates as high as over 90% at 6 weeks. Topical corticosteroids are also conditionally recommended as long-term treatment with very low-quality evidence in the 2020 treatment guidelines. Previous studies have indicated that a 50% dose reduction after initial induction therapy may still be effective in 73–93% of subjects, although more recent data suggest that loss of steroid response is common in adult patients who respond to topical steroids and is associated with dose reduction. When topical corticosteroids are used to treat EoE, we recommend repeat endoscopy after 8 to 12 weeks of induction therapy to assess histological response. If induction is successful, a reduction in steroid dose may be considered, taking into account patient response, preference, and potential side effects.
Another treatment option for EoE is elimination diets. While elemental diets alone are highly effective in managing EoE, their usefulness is limited due to low adherence rates. Therefore, they are generally reserved for patients refractory to other treatments. The allergy testing-directed elimination diet, based on the theory that eliminating allergens identified by allergy testing can effectively treat EoE when managed by an experienced allergist, is generally reliable and is less effective than empirical elimination diets. The six-food (milk, wheat, eggs, soy, peanuts/tree nuts, and shellfish) elimination diet (SFED) has been shown to achieve histologic remission rates of approximately 65% to 80%. However, a recent randomized trial found that the SFED led to histologic remission in 40% of patients after six weeks, which was not significantly different from the 34% remission rate achieved with a single-food (milk, alone) elimination diet. These findings suggest that a stepwise dietary approach that begins with a less restrictive diet and is intensified only if necessary, may improve treatment adherence while maintaining effectiveness. To address these limitations, simplified alternative diets have been developed, including two-food elimination diets (TFED) targeting major allergens such as milk and wheat, and four-food elimination diets (FFED) targeting the above two foods plus legumes and egg. These approaches achieve histological remission rates of approximately 40% to 50% and are considered more practical for clinical use. A step-up strategy, starting with a TFED and escalating to an FFED or SFED, if needed, has been shown to reduce the burden of dietary restrictions and endoscopic monitoring while maintaining therapeutic efficacy. Studies comparing dietary approaches in the treatment of EoE support empirical elimination diets as the preferred option for dietary treatment of EoE, with no data supporting the use of currently available allergy testing to guide specific food elimination diets. Currently, there is no cure for EoE, so long-term treatment is necessary.
Esophageal dilation is a safe and effective adjunctive treatment for esophageal strictures. Esophageal dilation does not address the underlying inflammatory process and is therefore recommended as an adjunct to maintenance therapy. Treatment algorithms recommend shared decision-making with the patient or family to determine appropriate therapeutic options, although PPIs, steroids, and elimination diets are typically considered first-line options. Expert consensus generally recommends that dupilumab be reserved for treatment failures, severe initial presentation (e.g., strictures), or superimposed atopic comorbidity (i.e., asthma/eczema/severe chronic rhinosinusitis with polyposis) of a severity that would also require dupilumab.
Currently, dupilumab, which interferes with the interleukin (IL)-4 and IL-13 pathways by binding to the IL-4 receptor α, is the only monoclonal antibody approved for the treatment of EoE. Dupilumab is an IgG4 monoclonal antibody that binds to the IL-4 receptor alpha subunit. It was initially approved in May 2022 for the treatment of several allergic disorders, such as atopic dermatitis and asthma, in adults and children 12 years and older. Subsequently (January 2024), the FDA expanded its indication to include pediatric patients aged 1 to 11 years and weighing at least 15 kg, making this approval the first therapy for EoE in this age group. EoE, a chronic allergic disease of the esophagus, progresses from a predominantly inflammatory to a fibrostenotic disease in most, but not all, patients. Guidelines recommend both maintenance treatment and long-term monitoring to assess disease activity. For example, an international group of EoE experts published monitoring recommendations highlighting the need to assess EoE activity in three domains (symptoms, endoscopic features, and histologic findings) after initial treatment, after a treatment change, and at some interval in patients in remission on maintenance treatment. However, data supporting these recommendations, particularly those related to monitoring intervals in patients in remission, are limited, and recommendations focus on individualizing intervals based on patient and disease characteristics. In a retrospective study, they observed that a ≥2-year interruption in care in patients with EoE was associated with signs of increased disease activity, and progression to fibrostenosis was observed, especially with longer interruptions. Since EoE can progress to fibrosis even after diagnosis, regular care, possibly at intervals of less than 2 years, is required.
Evidence suggests that long-term maintenance therapy may reduce the risk of esophageal stricture, bolus impaction, and the need for dilation in patients with EoE. More knowledge about the phenotypes of eosinophilic esophagitis is needed to determine who will benefit most from sustained therapy. Endoscopy is fundamental in the care and evaluation of patients with EoE. It is crucial for diagnosis, assessment of treatment response, treatment of esophageal strictures, and continuous monitoring of patients in histological remission, since less invasive tests to identify or classify the severity of EoE have not currently been established. Clinical, endoscopic, and histological follow-up is recommended to assess treatment response and to monitor patients on maintenance therapy. Evaluation and monitoring of inflammatory and fibrostenotic aspects of the disease should be considered.
One study concluded that a lack of care of ≥2 years in patients with EoE was associated with signs of increased disease activity, and progression to fibrostenosis was observed, particularly with longer periods of care. As EoE can progress to fibrosis even after diagnosis, regular follow-up is required in patients with EoE, possibly at intervals of <2 years.
Although existing evidence indicates that long-term maintenance therapy may reduce the risk of esophageal stricture, bolus impaction, and the need for dilation in patients with eosinophilic esophagitis, more knowledge about EoE phenotypes is needed to determine who will benefit most from sustained therapy. In the case of EoE triggered by an occupational allergen such as wheat flour, therapy would suffice by avoiding exposure to said allergen. However, if the allergen is also ingested, it should be restricted from the diet if it is confirmed that it also triggers EoE when ingested by the patient.
In conclusion, EoE is a chronic disease that exclusively affects the esophagus, which presents with TH2 inflammation with symptoms of esophageal dysfunction in adults, especially dysphagia and choking, and in children with swallowing disorders and nonspecific upper gastrointestinal symptoms. Diagnosis requires compatible symptoms and at least 15 eos/HPF after ruling out other causes of esophageal eosinophilia. The incidence and prevalence continue to increase at a faster rate than expected. Typical endoscopic signs are present, but not pathognomonic. It is associated with multiple atopic diseases and can have both short- and long-term complications. To minimize them, early diagnosis and good adherence to a correct initial and maintenance treatment are necessary, if it can be directed by a multidisciplinary team to obtain maximum profitability and minimum adverse effects.
References
- Erdle SC, Carr S, Chan ES, Robertson K, Watson W. Eosinophilic esophagitis. Allergy Asthma Clin Immunol. 2024 Dec 19;20(Suppl 3):72. Doi: 10.1186/s13223-024-00929-0.
- Horwitz A, Yunus S. Eosinophilic Esophagitis: A Review for the Primary Care Practitioner. Med Clin North Am. 2024 Jul;108(4):733-745. Doi: 10.1016/j.mcna.2023.08.010.
- Dellon ES, Muir AB, Katzka DA, Shah SC, Sauer BG, Aceves SS, Furuta GT, Gonsalves N, Hirano I. ACG Clinical Guideline: Diagnosis and Management of Eosinophilic Esophagitis. Am J Gastroenterol. 2025 Jan 1;120(1):31-59. Doi: 10.14309/ajg.0000000000003194. Epub 2025 Jan 2.
- Allin KH, Poulsen G, Melgaard D, Frandsen LT, Jess T, Krarup AL. Eosinophilic oesophagitis in Denmark: Population-based incidence and prevalence in a nationwide study from 2008 to 2018. United European Gastroenterol J. 2022 Sep;10(7):640-650. Doi: 10.1002/ueg2.12273. Epub 2022 Sep 15. PMID: 36106558;
- Garber JJ, Lochhead PJ, Uchida AM, Roelstraete B, Bergman D, Clements MS, Ludvigsson JF. Increasing incidence of eosinophilic esophagitis in Sweden: a nationwide population study. Esophagus. 2022 oct;19(4):535-541. Doi: 10.1007/s10388-022-00926-5. Epub 2022 Jun 2
- Sawada A, Imai T, Ihara Y, Tanaka F, Hirano I, Fujiwara Y. Epidemiology and Risk Factors of Eosinophilic Esophagitis in Japan: A Population-Based Study. Clin Gastroenterol Hepatol. 2024 oct;22(10):2023-2032.e6. Doi: 10.1016/j.cgh.2024.04.035.
- Roussel JM, Pandit S. Eosinophilic Esophagitis. 2023 Aug 8. In: StatPearls [Internet]. Treasure Island (FL): StatPearls Publishing; 2025 Jan–. PMID: 29083829
- Gautam Y, Caldwell J, Kottyan L, Chehade M, Dellon ES, Rothenberg ME, Mersha TB; Consortium of Eosinophilic Gastrointestinal Disease Researchers (CEGIR) investigators. Genome-wide admixture and association analysis identifies African ancestry-specific risk loci of eosinophilic esophagitis in African Americans. J Allergy Clin Immunol. 2023 May;151(5):1337-1350. Doi: 10.1016/j.jaci.2022.09.040.
- Muir A, Falk GW. Eosinophilic Esophagitis: A Review. JAMA. 2021 oct 5;326(13):1310-1318. Doi: 10.1001/jama.2021.14920
- Thel HL, Anderson C, Xue AZ, Jensen ET, Dellon ES. Prevalence and Costs of Eosinophilic Esophagitis in the United States. Clin Gastroenterol Hepatol. 2025 feb;23(2):272-280.e8. Doi: 10.1016/j.cgh.2024.09.03.
- Gratacós Gómez AR, Gómez Torrijos E. Eosinophilic Esophagitis due to Aeroallergens: A Systematic Review and Update. J Investig Allergol Clin Immunol. 2022 Dec 15;32(6):438-450. Doi: 10.18176/jiaci.0853.
- Lehman HK, Lam W. Eosinophilic Esophagitis. Immunol Allergy Clin North Am. 2021 Nov;41(4):587-598. Doi: 10.1016/j.iac.2021.07.011.
- Patel RV, Hirano I, Gonsalves N. Eosinophilic Esophagitis: Etiology and Therapy. Annu Rev Med. 2021 Jan 27; 72:183-197. Doi: 10.1146/annurev-med-052819-023848.
- Kennedy KV, Muir AB, Ruffner MA. Pathophysiology of Eosinophilic Esophagitis. Immunol Allergy Clin North Am. 2024 May;44(2):119-128. Doi: 10.1016/j.iac.2023.12.001.
- Ji R, Cui X, Zhi Y. Eosinophilic esophagitis and allergic susceptibility: A systematic review and meta-analysis. World Allergy Organ J. 2025 Apr 25;18(5):101054. Doi: 10.1016/j.waojou.2025.101054
- Alkhowaiter S. Eosinophilic esophagitis. Saudi Med J. 2023 Jul;44(7):640-646. Doi: 10.15537/smj.2023.44.7.20220812.
- Arias Á, Lucendo AJ. Molecular basis and cellular mechanisms of eosinophilic esophagitis for the clinical practice. Expert Rev Gastroenterol Hepatol. 2019 Feb;13(2):99-117. Doi: 10.1080/17474124.2019.1546120
- Fernandez-Becker NQ, Raja S, Scarpignato C, Lynch KL, Ahuja NK, Horsley-Silva JL. Eosinophilic esophagitis: updates on key unanswered questions. Ann N Y Acad Sci. 2020 Dec;1481(1):30-42. Doi: 10.1111/nyas.14421
- Lim AH, Wong S, Nguyen NQ. Eosinophilic Esophagitis and IgG4: Is There a Relationship? Dig Dis Sci. 2021 Dec;66(12):4099-4108. Doi: 10.1007/s10620-020-06788-0.
- McGowan EC, Singh R, Katzka DA. Barrier Dysfunction in Eosinophilic Esophagitis. Curr Gastroenterol Rep. 2023 Dec;25(12):380-389. Doi: 10.1007/s11894-023-00904-6. Epub 2023 Nov 11
- Underwood B, Troutman TD, Schwartz JT. Breaking down the complex pathophysiology of eosinophilic esophagitis. Ann Allergy Asthma Immunol. 2023 Jan;130(1):28-39. Doi: 10.1016/j.anai.2022.10.026.
- Sciumè GD, Visaggi P, Sostilio A, et al. Esofagitis eosinofílica: nuevos conceptos sobre patogénesis y manifestaciones clínicas. Minerva Gastroenterology. Marzo de 2022;68(1):23-39. DOI: 10.23736/s2724-5985.20.02807-x.
- de Bortoli N, Visaggi P, Penagini R, Annibale B, Baiano Svizzero F, Barbara G, Bartolo O, Battaglia E, Di Sabatino A, De Angelis P, Docimo L, Frazzoni M, Furnari M, Iori A, Iovino P, Lenti MV, Marabotto E, Marasco G, Mauro A, Oliva S, Pellegatta G, Pesce M, Privitera AC, Puxeddu I, Racca F, Ribolsi M, Ridolo E, Russo S, Sarnelli G, Tolone S, Zentilin P, Zingone F, Barberio B, Ghisa M, Savarino EV. The 1st EoETALY Consensus on the Diagnosis and Management of Eosinophilic Esophagitis – Definition, Clinical Presentation and Diagnosis. Dig Liver Dis. 2024 jun;56(6):951-963. Doi: 10.1016/j.dld.2024.02.005.
- Visaggi P, Savarino E, Sciume G, Chio TD, Bronzini F, Tolone S, Frazzoni M, Pugno C, Ghisa M, Bertani L, Bellini M, Savarino V, Peroni D, Marchi S, de Bortoli N. Eosinophilic esophagitis: clinical, endoscopic, histologic and therapeutic differences and similarities between children and adults. Therap Adv Gastroenterol. 2021 Jan 31; 14:1756284820980860. Doi: 10.1177/1756284820980860.
- Xu X, Kwiatek J, Siddall J, Genofre E, Stirnadel-Farrant H, Katial R. Patient-reported symptoms and burden of eosinophilic esophagitis: evidence from real-world clinical practice. BMC Gastroenterol. 2024 Aug 3;24(1):246. Doi: 10.1186/s12876-024-03334-4
- Taft TH, Carlson DA, Simons M, Zavala S, Hirano I, Gonsalves N, Pandolfino JE. Esophageal Hypervigilance and Symptom-Specific Anxiety in Patients with Eosinophilic Esophagitis. Gastroenterology. 2021 Oct;161(4):1133-1144. Doi: 10.1053/j.gastro.2021.06.023. Epub 2021 Jun 19. PMID: 34153298.
- Chang JW, Chen VL, Rubenstein JH, Dellon ES, Wallner LP, De Vries R. What patients with eosinophilic esophagitis may not share with their providers: a qualitative assessment of online health communities. Dis Esophagus. 2022 Jun 15;35(6):doab073. Doi: 10.1093/dote/doab073
- Gold BD, Goodwin B, Davis K, Sweeney C, Reynolds M, Jiang J, Fan T, Boules M, Chen ST, Katzka DA. Health-Related Quality of Life and Perceived Stigma in Eosinophilic Esophagitis: A Real-World, US, Web-Based Survey. Gastro Hep Adv. 2024 Jul 30;3(8):1087-1097. Doi: 10.1016/j.gastha.2024.07.015
- Rooij WE, Evertsz FB, Lei A, Bredenoord AJ. General Well-being and Coping Strategies in Adult Eosinophilic Esophagitis Patients. J Neurogastroenterol Motil. 2022 Jul 30;28(3):390-400. Doi: 10.5056/jnm21143.
- Schreiner P, Safroneeva E, Rossel JB, Limacher A, Saner C, Greuter T, Schoepfer A, Straumann A, Biedermann L. Sex Impacts Disease Activity But Not Symptoms or Quality of Life in Adults With Eosinophilic Esophagitis. Clin Gastroenterol Hepatol. 2022 Aug;20(8):1729-1738.e1. Doi: 10.1016/j.cgh.2021.11.009.
- Meyer R, Cianferoni A, Vazquez-Ortiz M. An update on the diagnosis and management of non-IgE-mediated food allergies in children. Pediatr Allergy Immunol. 2025 Mar;36(3):e70060. Doi: 10.1111/pai.70060. PMID: 40110885.
- Hoerning A, Steiss JO, Madisch A, de Laffolie J. Eosinophilic Esophagitis: Prevalence, Diagnosis, and Treatment in Childhood and Adulthood. Dtsch Arztebl Int. 2025 Apr 4;(Forthcoming): arztebl.m2025.0042. Doi: 10.3238/arztebl.m2025.0042
- O’Shea D, Quinn E, Middlesworth W, Khlevner J. Diagnosis and Management of Long-term Gastrointestinal Complications in Pediatric Esophageal Atresia/Tracheoesophageal Fistula. Curr Gastroenterol Rep. 2025 Feb 25;27(1):16. Doi: 10.1007/s11894-025-00968-6.
- Farah A, Assaf T, Hindy J, Abboud W, Mahamid M, Savarino EV, Mari A. The Dynamic Evolution of Eosinophilic Esophagitis. Diagnostics (Basel). 2025 Jan 21;15(3):240. Doi: 10.3390/diagnostics15030240.
- Barchi A., Vespa E., Passaretti S., Dell’anna G., Fasulo E., Yacoub M.-R., Albarello L., Sinagra E., Massimino L., Ungaro F., et al. The Dual Lens of Endoscopy and Histology in the Diagnosis and Management of Eosinophilic Gastrointestinal Disorders-A Comprehensive Review. Diagnostics. 2024; 14:858. Doi: 10.3390/diagnostics14080858
- de Bortoli N., Visaggi P., Penagini R., Annibale B., Svizzero F.B., Barbara G., Bartolo O., Battaglia E., Di Sabatino A., De Angelis P., et al. The 1st EoETALY Consensus on the Diagnosis and Management of Eosinophilic Esophagitis—Current Treatment and Monitoring. Dig. Liver Dis. Off. J. Ital. Soc. Gastroenterol. Ital. Assoc. Study Liver. 2024; 56:1173–1184. Doi: 10.1016/j.dld.2024.02.020.
- Gupta M, Grinman M. Diagnosis and management of eosinophilic esophagitis. CMAJ. 2024 feb 4;196(4): E121-E128. Doi: 10.1503/cmaj.230378
- Papadopoulou A., Amil-Dias J., Auth M.K.H., Chehade M., Collins M.H., Gupta S.K., et al. Joint ESPGHAN/NASPGHAN guidelines on childhood eosinophilic gastrointestinal disorders beyond eosinophilic esophagitis. J Pediatr Gastroenterol Nutr. 2024; 78:122–152. Doi: 10.1097/MPG.0000000000003877.
- Gonzalez-Uribe V, Hernandez-Zarate LA, Pozo Beltran CF, Alcocer-Arreguin CR, de Baro Alvarez P, Coello-Niembro N, Jimenez-Feria P, Mojica Gonzalez ZS, Gomez-Nuñez CA, Martinez-Tenopala R, Basile-Alvarez MR, Velasco-Benhumea B, Fernandez-Soto R, García-Fajardo DE, Perez-Avilés H, Pinto-Solis C, Rios-Villalobos LA, Ureña-Ortiz R, Lezama-Vazquez L, Acosta-Rodriguez-Bueno P, Del Rio-Navarro BE. Eosinophilic esophagitis in children: A multicenter study evaluating current practices in Mexico. J Allergy Clin Immunol Glob. 2024 Dec 18;4(1):100392. Doi: 10.1016/j.jacig.2024.100392
- Almazan E, Liang TZ, Hohl B, Hoskins BJ, Birkness-Gartman JE, Ng K. EndoFLIP distensibility index correlates with histologic findings in children with eosinophilic esophagitis. J Pediatr Gastroenterol Nutr. 2025 May;80(5):824-831. Doi: 10.1002/jpn3.70013.
- Lin B, Rabinowitz S, Haseeb MA, Gupta R. Usefulness of the eosinophilic esophagitis histologic scoring system in distinguishing active eosinophilic esophagitis from remission and gastroesophageal reflux disease. Gastroenterol Res. 2021; 14(4): 220-226.
- Hoffmann NV, Keeley K, Wechsler JB. Esophageal distensibility defines fibrostenotic severity in pediatric eosinophilic esophagitis. Clin Gastroenterol Hepatol. 2023; 21: 1188-1197.e4. Doi:10.1016/j.cgh.2022.08.044
- Sykes C.M., Fairlamb G.M., Fox M.M., Sweis R. Assessment of Esophageal Motility in Patients With Eosinophilic Esophagitis: A Scoping Review. J. Clin. Gastroenterol. 2023;57:10–30. Doi: 10.1097/MCG.0000000000001792.
- Nguyen N, Lavery WJ, Capocelli KE, Smith C, DeBoer EM, Deterding R, Prager JD, Leinwand K, Kobak GE, Kramer RE, Menard-Katcher C, Furuta GT, Atkins D, Fleischer D, Greenhawt M, Friedlander JA. Transnasal Endoscopy in Unsedated Children With Eosinophilic Esophagitis Using Virtual